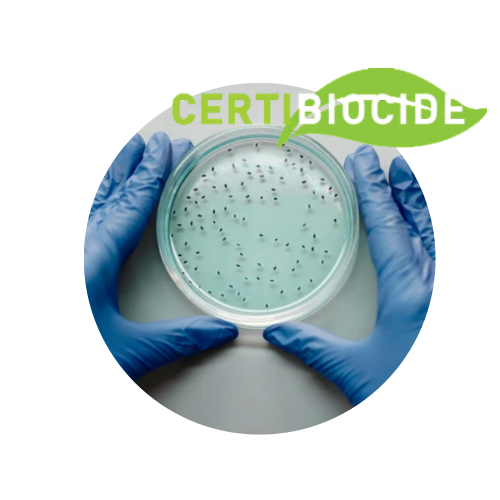

RS6440 – Certificat individuel pour utiliser à titre professionnel et distribuer certains types de produits biocides
catégorie désinfectants
Objectifs et contexte de la certification :
Le dispositif de certificat individuel pour l’activité d’utilisateur professionnel et de distributeur de certains types de produits biocides, dit « certibiocide » vise à certifier les compétences des utilisateurs, acheteurs, vendeurs de certains produits biocides réservés aux professionnels.
La catégorie « désinfectants » concerne les décideurs, les acquéreurs et les distributeurs de produits désinfectants (TP2, TP3 et TP4) réservés à l’usage professionnel.
Cette certification vise à certifier les personnes concernées par ces produits afin que celles-ci disposent d’un niveau de compétences suffisant et adapté permettant une utilisation raisonnée, durable et sûre de ces produits biocides pour, notamment, protéger l’environnement et les populations tierces exposées à ces produits via leur activité.
Compétences attestées :
- Connaître la réglementation sur les produits désinfectants.
- Comprendre les risques liés à l’utilisation des produits désinfectants et maîtriser les mesures de protection à mettre en place pour prévenir les risques pour la santé et l’environnement.
- Contribuer à limiter le recours aux produits désinfectants en privilégiant des alternatives non chimiques.
- Assurer une utilisation durable des produits désinfectants dans le cadre d’une activité professionnelle.
- Connaître les bonnes pratiques pour gérer les déchets liés à l’utilisation des produits désinfectants (gestion des effluents, des déchets organiques,…).
Modalités d’évaluation :
- Vérification de l’acquisition des compétences via un test de 30 questions validé par le ministère.
- 20/30 mini nécessaire pour valider l’obtention de la certification.
- Si résultat inférieur à 20/30 = formation complémentaire de consolidation des compétences avant d’obtenir la certification.